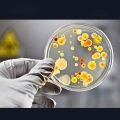
Plastic Petri Dishes 60mm to 90mm – Pack of 10 ( 1-6 Packs ) – Grid & Single Compartment, Stackable, Transparent, Vented – Perfect for Lab Work, Research, Bacteria & Fungi Culture, Science Experiments, School Projects, & Microbiology Study.
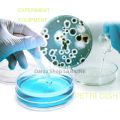
Plastic Petri Dishes 60mm to 90mm – Pack of 10 ( 1-6 Packs ) – Grid & Single Compartment, Stackable, Transparent, Vented – Perfect for Lab Work, Research, Bacteria & Fungi Culture, Science Experiments, School Projects, & Microbiology Study.

10 Pieces 90mm
Help & Support
زبان تبدیل کریں
UR / Urdu
EN / English
Categories